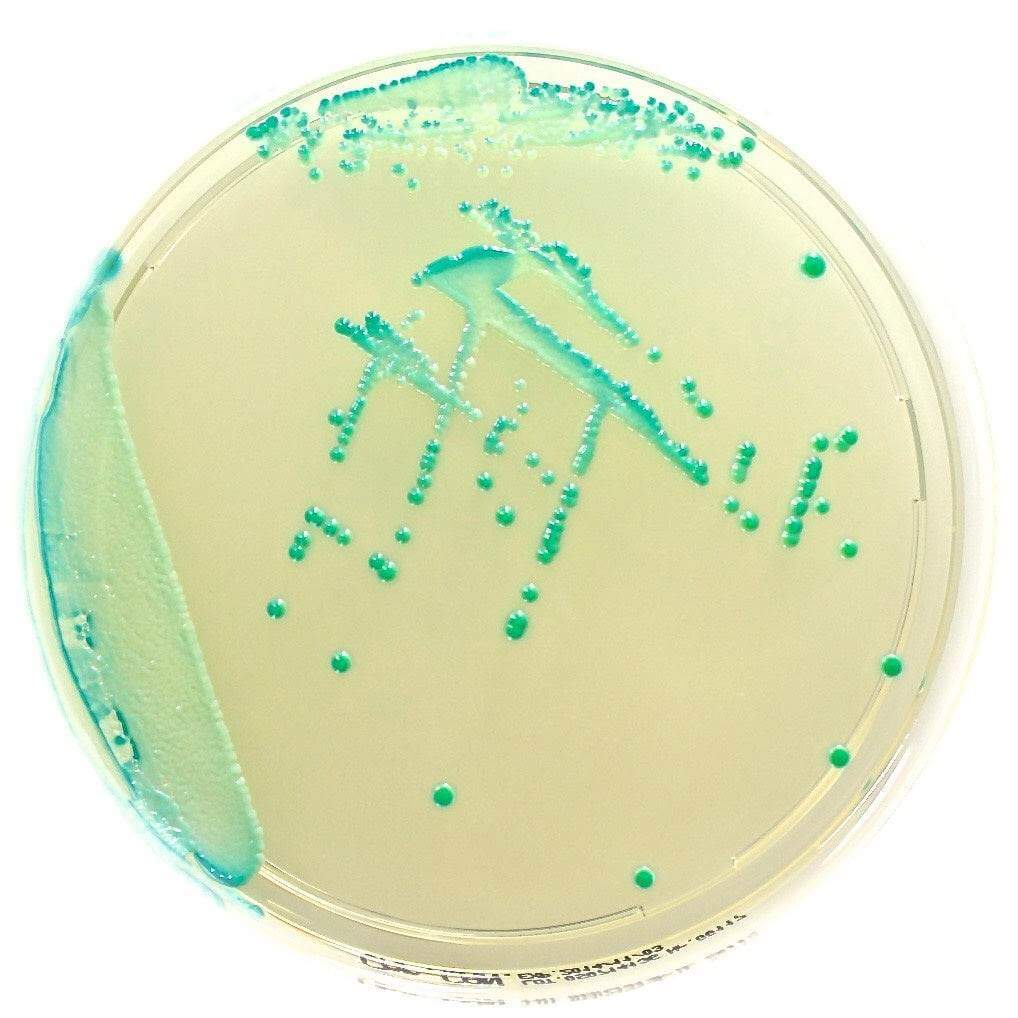
Chromatic Candida - Kormay Biomedicals store
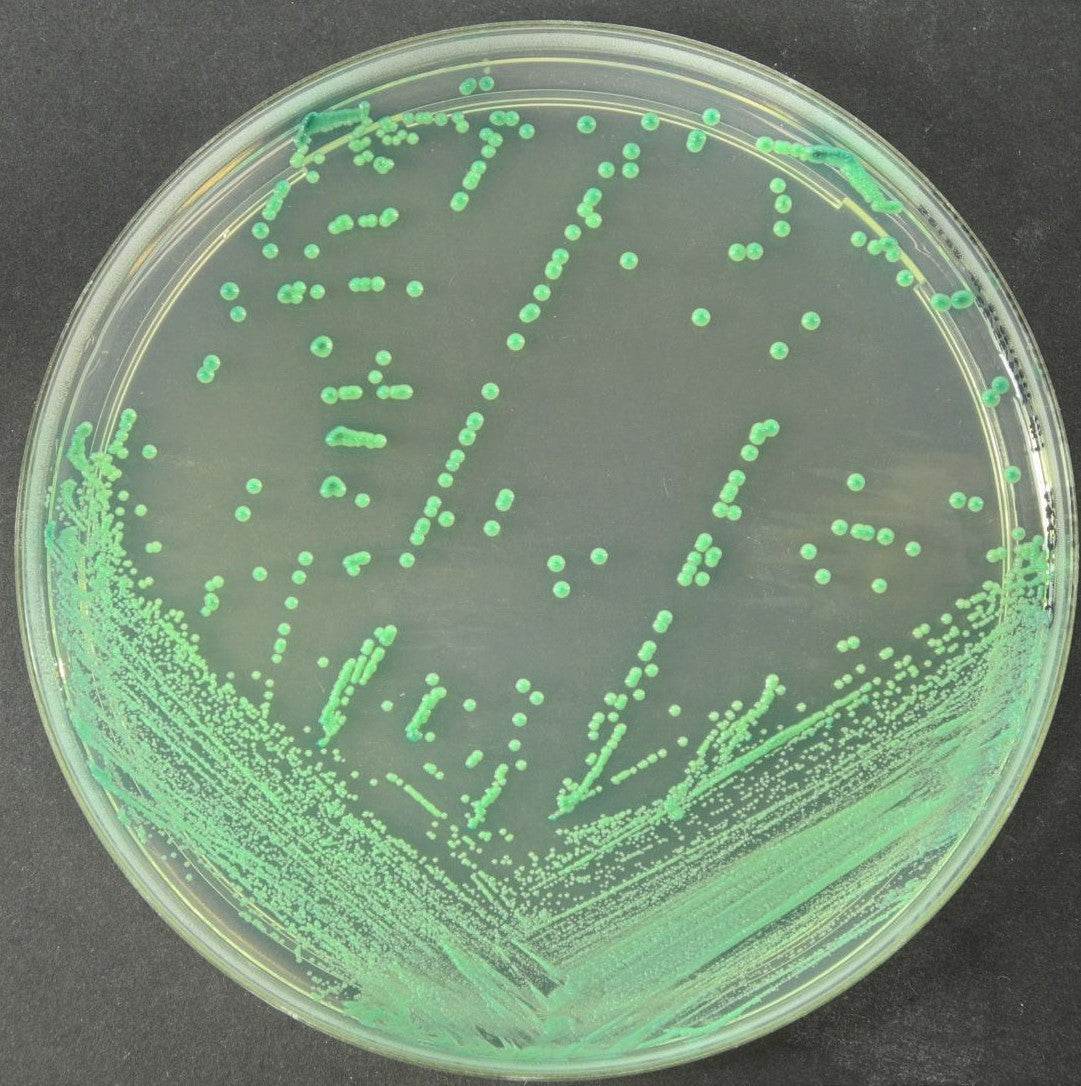
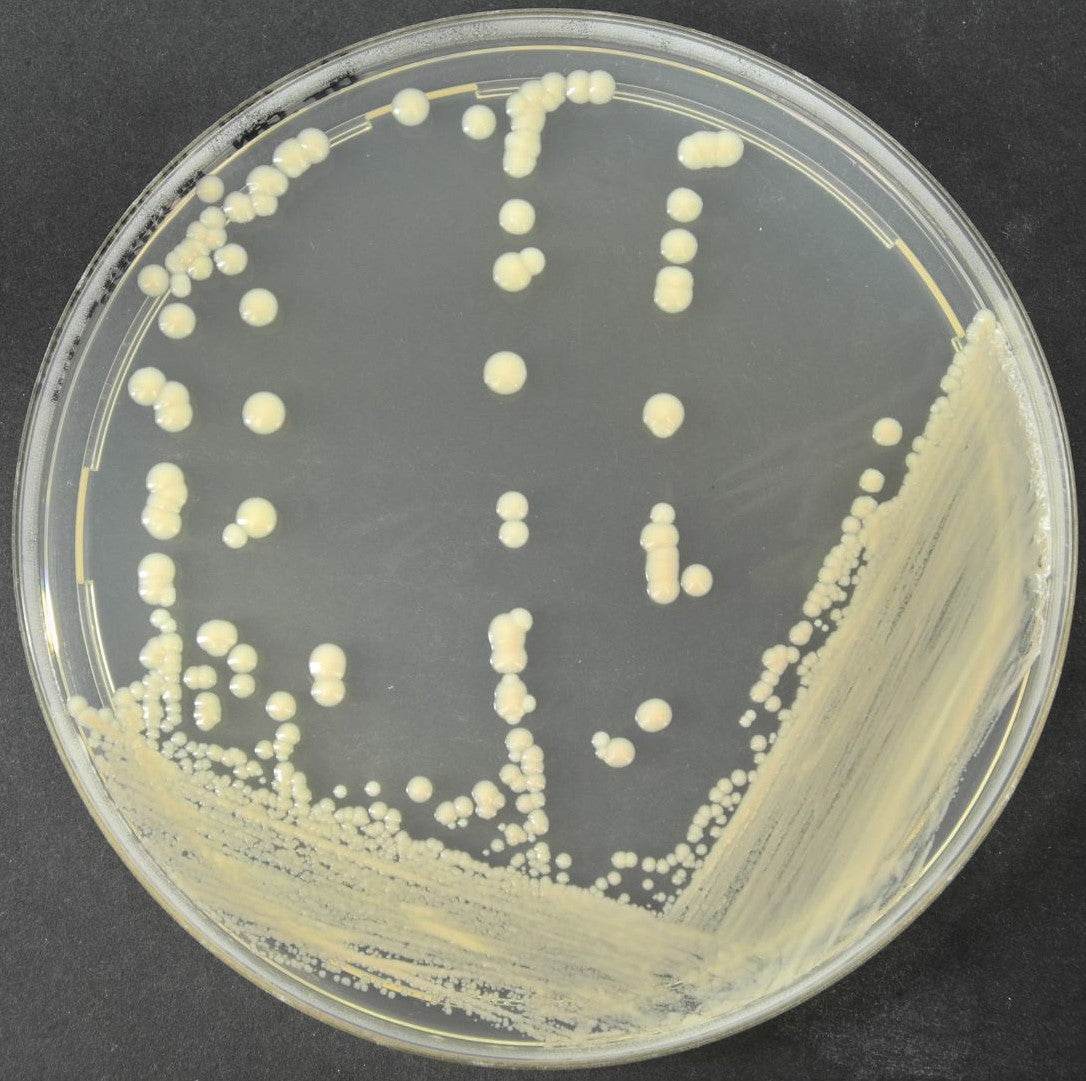

Description
Chromogenic selective medium for the isolation and differentiation of Candida spp directly from clinical and nonclinical specimens.
ChromaticTM Candida is a chromogenic selective medium used for the isolation and differentiation of Candida species directly from clinical and nonclinical specimens permitting to distinguish among C.albicans, C.tropicalis, C.krusei, C.glabrata, C.dubliniensis and C.parapsilosis.
Although Candida albicans remains the most common cause of human Candidiasis, the frequency of infection attributed to other members of the genus is also increasing. Effective treatment requires both early diagnosis and prompt initiation of therapy against fungal infection.
Disclaimer: This product is for laboratory use only.
Payment & Security
Your payment information is processed securely. We do not store credit card details nor have access to your credit card information.